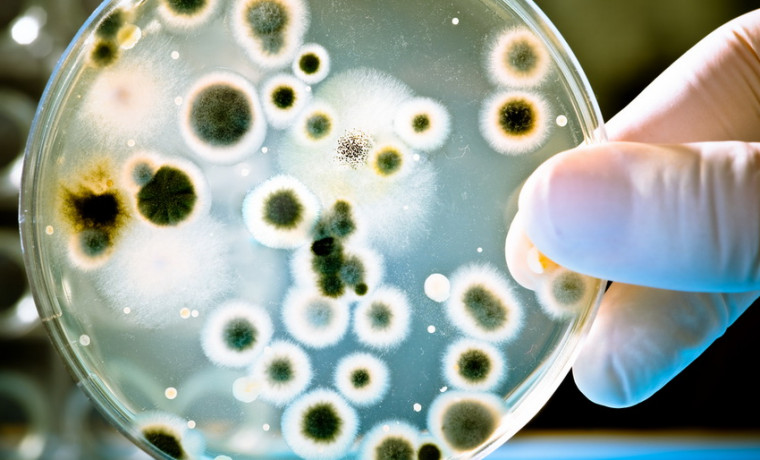

На карибском острове Гваделупа ученые обнаружили гигантских бактерий
Французские и американские микробиологи обнаружили в мангровых лесах на карибском острове Гваделупа ранее неизвестный вид гигантских бактерий, чьи клетки достигают длины почти в сантиметр, сообщает ТАСС со ссылкой на пресс-службу Национальной лаборатории имени Лоуренса (LBNL).
"Эта бактерия примерно в пять тысяч раз больше, чем большинство других микробов. Это эквивалентно тому, если бы мы встретили человека ростом с гору Эверест. При этом самая необычная черта данного микроба заключается в том, что копии его генома содержатся в обособленных структурах, окруженных мембраной. Это крайне нетипично для бактерий", - заявил научный сотрудник LBNL Жан-Мари Воллан.
Большинство существующих на Земле микробов обладает крайне миниатюрными размерами, однако некоторые бактерии, в частности морские микробы Thiomargarita namibiensis, не уступают в размерах многим видам амеб и других простейших. Группа биологов под руководством Воллана обнаружила у берегов тропического острова Гваделупа еще более крупного микроба, получившего имя Thiomargarita magnifica.
Ученые совершили это открытие в ходе изучения образцов морской воды, собранных в окрестностях прибрежных мангровых лесов. Как отмечают биологи, в этих пробах присутствовали не только листья деревьев и различный мусор, но и белые полупрозрачные нити длиной почти в сантиметр, похожие на сверхтонкую "стеклянную лапшу". Когда биологи изучили их под микроскопом, они обнаружили, что эти структуры представляют собой пока самых крупных бактерий на Земле.











